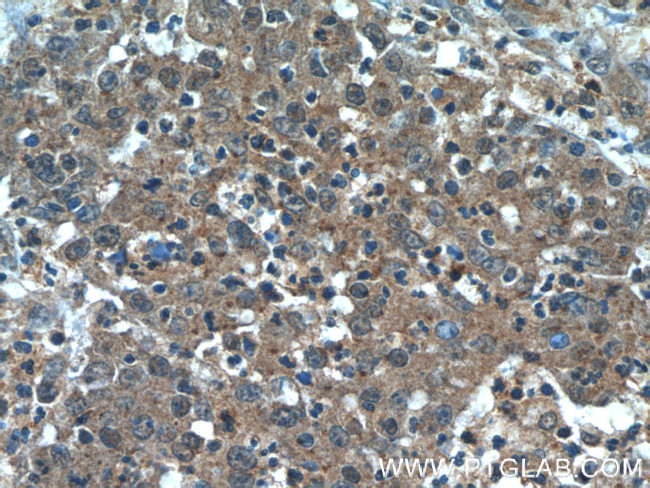
Transgelin 2 Antibody in Immunohistochemistry (Paraffin) (IHC (P))

Search
Proteintech
Transgelin 2 Monoclonal Antibody (2E5G1)
{{$productOrderCtrl.translations['antibody.pdp.commerceCard.promotion.promotions']}}
{{$productOrderCtrl.translations['antibody.pdp.commerceCard.promotion.viewpromo']}}
{{$productOrderCtrl.translations['antibody.pdp.commerceCard.promotion.promocode']}}: {{promo.promoCode}} {{promo.promoTitle}} {{promo.promoDescription}}. {{$productOrderCtrl.translations['antibody.pdp.commerceCard.promotion.learnmore']}}
产品信息
60044-1-IG
种属反应
宿主/亚型
分类
类型
克隆号
抗原
偶联物
形式
浓度
规格
纯化类型
保存液
内含物
保存条件
运输条件
产品详细信息
Our test results showed that this antibody Is specific to TAGLN2. It does not bind TAGLN1 and TAGLN3.
Immunogen sequence: RGPAYGLSR EVQQKIEKQY DADLEQILIQ WITTQCRKDV GRPQPGRENF QNWLKDGTVL CELINAQYPE GQAPVKKIQA STMAFKQMEQ ISQFLQAAER YGINTTDIFQ TVDLWEGKNM ACVQRTLM (4-130 aa encoded by BC002616)
靶标信息
Transgelin (also designated SM22alpha), is expressed abundantly in smooth muscle cells. Transgelin-2 (also known as SM22alpha homolog) is a homolog of transgelin and is also expressed in smooth muscle cells and by peritoneal B-1 cells. The human transgelin-2 gene (designated TAGLN2), which is located on chromosome 1q231-q25, encodes a 199 amino acid protein that contains a calponin-like repeat and a calponin-homology (CH) domain. Transgelin-2 may function very similarly to transgelin. During embryogenesis, transgelin is expressed in smooth, cardiac and skeletal muscle, but is restricted during late fetal development and adulthood to all vascular and visceral smooth muscle cells and low levels of expression in heart. Transgelin is downregulated in several transformed cell lines, indicating that a reduction of transgelin expression may be an early indicator of the onset of transformation. Transgelin also binds actin, causing actin fibers to gel within minutes of binding. Binding of transgelin to actin occurs at a ratio of 1:6 actin monomers.
仅用于科研。不用于诊断过程。未经明确授权不得转售。
生物信息学
蛋白别名: epididymis secretory sperm binding protein; Epididymis tissue protein Li 7e; KIAA0120; similar to Homo sapiens mRNA for KIAA0120 gene with GenBank Accession Number D21261.1; SM22-alpha homolog; SM22-beta; TAGLN2; Transgelin-2; unnamed protein product
基因别名: 2700094C18Rik; CDABP0035; HA1756; KIAA0120; Sm22a; Sm22B; SM22beta; TAGLN2
UniProt ID: (Human) P37802, (Mouse) Q9WVA4
Entrez Gene ID: (Human) 8407, (Mouse) 21346